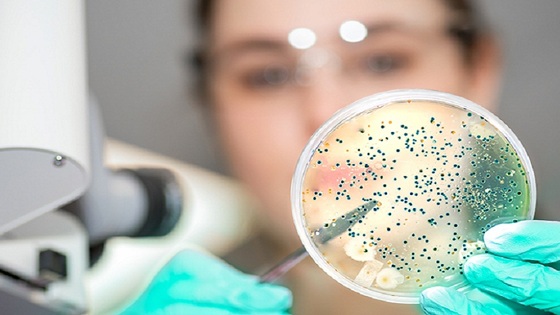

Ученые рассказали о пользе пробиотиков в профилактике гриппа и COVID-19
Для того, чтобы сформировать крепкий иммунитет, способный противостоять вирусам гриппа и ковид, необходимо наладить работу кишечника. Об этом исследователи рассказали в журнале, опубликованном в Clinical Nutrition.
Поэтому ученые рекомендуют принимать пробиотики, содержащие лактобактерии Lacticaseibacillus rhamnosus.
Исследование с участием добровольцев во время пандемии ковид показало, что при ежедневном употреблении 10 миллиардов КОЭ L. Rhamnosus в течение месяца, можно сформировать иммунитет, который противостоит заражению даже при близком контакте с больным ковид или гриппом.
В результате эксперимента только 26,4% добровольцев, принимавших пробиотик, заболели ковидом или ОРВИ.
В группе, получавшей плацебо, таких оказалось 42,9%.
Ранее эксперты рассказали, что по утрам помогает проснуться теплая лимонная вода, а клюква помогает продлить жизнь на 31%.